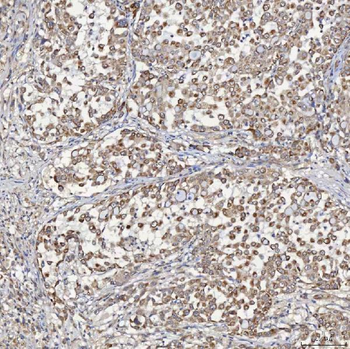
ACAD9 Rabbit Polyclonal Antibody

You have no items in your shopping cart.
All Products
- SQSTM1/p62 Mouse Monoclonal Antibody [orb570318]
FC, ICC, IF, IHC, WB
Human, Mouse, Rat
Mouse
Monoclonal
Unconjugated
100 μg - RAB27A Mouse Monoclonal Antibody [orb570319]
FC, ICC, IF, IHC, WB
Human, Mouse, Rat
Mouse
Monoclonal
Unconjugated
100 μg - Cofilin 2/CFL2 Mouse Monoclonal Antibody [orb570307]
FC, ICC, IF, IHC, WB
Human, Mouse, Rat
Mouse
Monoclonal
Unconjugated
100 μg - BAK/BAK1 Mouse Monoclonal Antibody [orb570309]
FC, ICC, IF, IHC, WB
Human, Mouse, Rat
Mouse
Monoclonal
Unconjugated
100 μg - SGCE Rabbit Polyclonal Antibody [orb1402082]
ELISA, FC, IHC, WB
Human, Mouse, Rat
Rabbit
Polyclonal
Unconjugated
100 μg - SDF2L1 Rabbit Polyclonal Antibody [orb1402166]
ELISA, IF, IHC, WB
Human, Mouse, Rat
Rabbit
Polyclonal
Unconjugated
100 μg - TRIM16 Rabbit Polyclonal Antibody [orb1402136]
ELISA, FC, ICC, IHC, WB
Human, Rat
Rabbit
Polyclonal
Unconjugated
100 μg - SFXN3 Rabbit Polyclonal Antibody [orb1402084]
ELISA, FC, IF, IHC, WB
Human
Rabbit
Polyclonal
Unconjugated
100 μg - SART1 Rabbit Polyclonal Antibody [orb1402181]
ELISA, FC, ICC, IF, IHC, WB
Human, Mouse, Rat
Rabbit
Polyclonal
Unconjugated
100 μg - ACAD9 Rabbit Polyclonal Antibody [orb1402113]
ELISA, FC, IF, IHC, WB
Human
Rabbit
Polyclonal
Unconjugated
100 μg